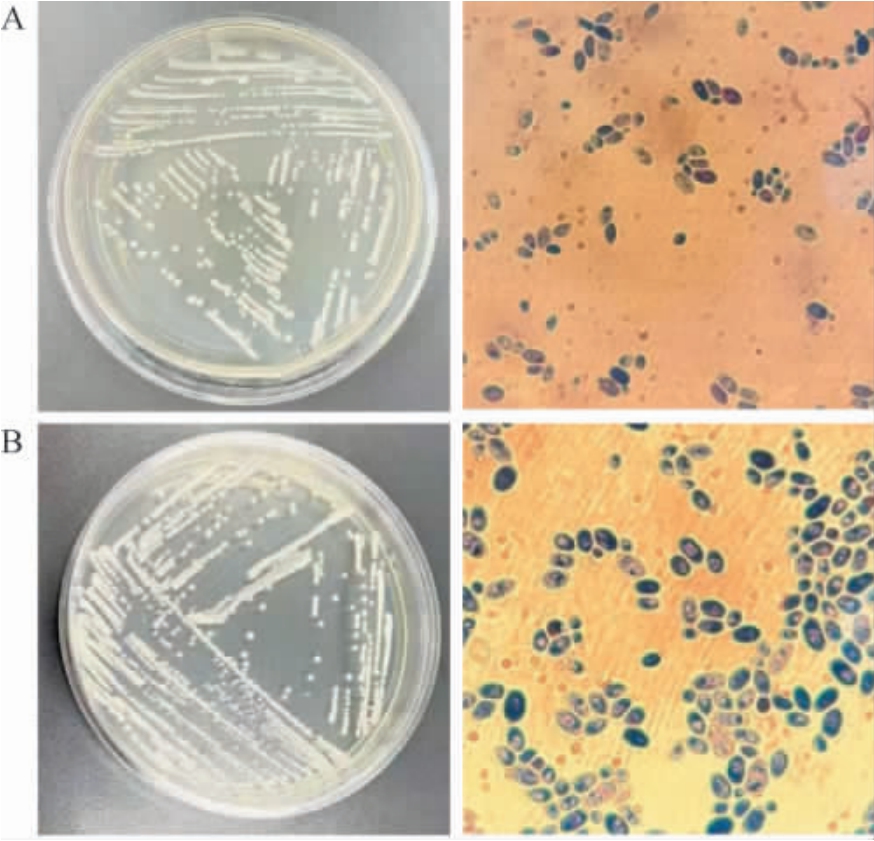

发酵乳是指以生牛(羊)乳等为原料,经杀菌、发酵后制成的一类pH降的产品[1]。内蒙古地区传统发酵乳制品具有独特的风味、丰富的营养价值及独特的口感[2],更易被人体摄取利用[3]。马奶酒、奶酪、奶皮子、奶豆腐、乳扇等传统发酵乳中存在大量微生物,其中酵母菌作为兼性厌氧生物[4],能够在有氧与无氧环境中生存。凭借独特的代谢机制,酵母菌可将糖类高效转化为酒精与二氧化碳,发酵性能优良[5]。对产品风味的形成、营养价值的提升具有重要作用[6-9]。微生物产脂肪酶[10]和蛋白酶[11]可增强奶制品风味。
关于传统发酵乳制品中酵母菌的研究集中在菌株筛选及发酵性能等方面。 张晓旭等[12-13]从内蒙古和新疆牧区酸马奶中筛选出喜仙人掌毕赤酵母(Pichia cactophila)、马克斯克鲁维酵母(Kluyveromyces marxianus)、涎沫假丝酵母(Candida zeylanoides)及酿酒酵母(Saccharomyces cerevisiae)等性能优良的酵母菌。刘飞等[14]从新疆哈萨克族奶酪筛选产脂肪酶酵母菌并优化了其产酶条件,结果表明,K.marxianus Z-5产脂肪酶活性可达25.99 U/mL。乔传丽等[15]从传统发酵酸牛奶中筛选产蛋白酶酵母菌并优化了产酶条件,结果表明,Pichia kudriavzevii D1-3、K.marxianus S1-7最佳产蛋白酶活力分别达78 U/mL、79 U/mL。单一产酶菌株不能满足酶类生产的需求,产酶酵母菌方面的研究鲜见报道。
本研究从酸奶、马奶酒、干酪等从传统发酵乳制品中分离筛选具有产蛋白酶和脂肪酶活性的酵母菌,对筛选菌株进行耐受性以及发酵性能实验,通过形态学观察、分子生物学技术对筛选菌株进行鉴定,并对其生长曲线、最佳产酶条件进行分析。 旨在丰富乳制品微生物资源,为产酶酵母菌菌株的利用提供理论依据。
1 材料与方法
1.1 材料与试剂
1.1.1 材料
酸奶、马奶酒、干酪等传统发酵乳制品:来自内蒙古赤峰市、锡林郭勒盟、通辽市和兴安盟。
1.1.2 试剂
氯化钠:天津科密欧化学试剂有限公司;蛋白胨、琼脂粉、三丁酸甘油酯:大连美伦生物技术有限公司;酵母浸粉:青岛海博生物技术有限公司。 所有试剂均为分析纯或生化试剂。
1.1.3 培养基
酵母浸出粉胨葡萄糖培养基(yeast extract peptone dextrose,YPD)液体培养基、YPD固体培养基、酪蛋白琼脂培养基:青岛海博生物技术有限公司。
三丁酸甘油酯琼脂培养基:蛋白胨10 g/L,酵母浸粉5 g,氯化钠10 g,琼脂粉20 g,三丁酸甘油酯2 mL,加入1 000 mL的去离子水。
富集培养基:酵母浸粉6 g,KH2PO4 1 g,Na2HPO4 2 g,NaCl 0.5 g,MgSO4·7H2O 1 g,橄榄油10 mL/L,pH 6.0,水1 000 mL。
以上培养基均于121 ℃灭菌20 min。
1.2 仪器与设备
DL-CJ-2ND1洁净工作台:北京东联哈尔仪器制造有限公司;LDZX-50KB立式压力蒸汽灭菌锅:上海申安医疗器械厂;LRH-500F恒温生化培养箱:上海慧泰仪器有限公司;H/T16MM台式高速离心机:湖南赫西仪器装备有限公司;JZ-SY振荡培养箱:鹤壁精中科技有限公司;722型分光光度计:上海精科仪器有限公司;CX23光学显微镜:奥林巴斯(中国)有限公司。
1.3 方法
1.3.1 产酶酵母菌的富集
称取5 g样品,溶入盛有50 mL无菌水的锥形瓶内,摇匀后置于28 ℃、180 r/min的摇床上振荡6 h,待瓶内的溶液静置分层,取5 mL上清液加入到盛有50 mL液体富集培养基的锥形瓶中,再置于28 ℃、175 r/min的摇床内振荡培养24 h,进行富集培养。
1.3.2 酵母菌的分离与纯化
取1 mL样液于9 mL无菌水中充分混匀,进行10倍梯度稀释,分别吸取100 μL稀释度为10-5、10-6、10-7的稀释液于含100 mg/L氯霉素的YPD固体培养基(含氯霉素),涂布均匀后倒置于28 ℃培养箱中培养48 h。挑取典型酵母菌菌落(细胞形态呈圆形或椭圆形、腊肠状且细胞较大),分别划线接种于YPD固体培养基,重复2~3次划线分离、纯化后得到酵母菌纯培养物,进行甘油保藏[16]。
1.3.3 高产酶酵母菌的筛选
(1)产脂肪酶酵母菌的筛选
将活化后得酵母菌接种于YPD液体培养基中于28 ℃培养48 h,取1 mL菌悬液于9 mL生理盐水(0.9%)中充分混匀,进行10倍梯度稀释,取200 μL稀释度为10-4、10-5、10-6的稀释液涂布于三丁酸甘油酯培养基平板,置于30 ℃条件下培养3~5 d后观察其透明圈,产生透明圈的菌株具有产脂肪酶能力,并记录透明圈直径(D)、菌落直径(d),选择透明圈直径与菌落直径比值(D/d)较大的菌株进行筛选。
(2)产蛋白酶酵母菌的筛选
将活化后得酵母菌接种于YPD液体培养基中于28 ℃培养48 h,取1 mL菌悬液于9 mL生理盐水(0.9%)中充分混匀,进行10倍梯度稀释,采取200 μL稀释度为10-4、10-5、10-6的稀释液涂布于酪蛋白琼脂培养基中,置于28 ℃条件下培养48 h后观察其透明圈,产生透明圈的菌株具有产蛋白酶能力,并记录直径透明圈直径(D)、菌落直径(d),选择透明圈直径与菌落直径比值(D/d)较大的菌株进行筛选。
1.3.4 酵母菌耐受性
分别将菌株按2%(V/V)接种量接种至不同葡萄糖含量(10%、20%、30%、40%、50%)、不同乙醇体积分数(5%、7%、9%、11%、13%)、不同pH值(2.0、2.5、3.0、3.5、4.0)的YPD液体培养基中,28 ℃培养24 h,测定波长600 nm处的吸光度值(OD600nm值)。
1.3.5 酵母菌产香能力
参考李宇辉等[13]的方法,将筛选产酶酵母菌接种于YPD液体培养基,于28 ℃条件下培养48 h,从醇香、酯香、不良气味、其他气味及总体可接受度5个方面对产香能力进行评价,分为未发觉(1分)、中等(2~5分)、较浓(6~9分)及强烈(10分)4个方面进行感官评价。
1.3.6 分子生物学鉴定
提取菌株基因组DNA,选用通用引物ITS1F(5'-CTTGGTCATTTAGAGGAAGTAA-3')和ITS4R4(5'-TCCTCCGCTTATTGATATGC-3')对菌株18S rRNA基因进行扩增ITS并测序[17],PCR扩增体系和扩增条件参考马文锦等[18]的方法。将PCR扩增产物送至北京百泰派克生物科技有限公司测序。 将测序结果在美国国家生物技术信息中心(national center for biotechnology information,NCBI)数据库中进行局部比对搜索工具(basic local alignment search tool,BLAST)比对分析[19],利用MEGA 11.0软件的邻接(neighbor-joining,NJ)法构建系统发育树。
1.3.7 生长曲线测定
将筛选的产酶酵母菌以5%(V/V)的接种量接种于YPD液体培养基中,28 ℃静置培养3 d,分别在0 h、12 h、24 h、36 h、48 h、60 h、72 h取样于600 nm波长下测定OD600nm值,平行测定3次取其平均值。
1.3.8 酵母菌产酶条件优化
将筛选出的产酶酵母菌接种到装液量为50 mL/250 mL的YPD液体发酵培养基中,于28 ℃、180 r/min培养1~2 d,10 000 r/min离心15 min,取上清液。参考刘飞等[14-15]的方法,分别调整发酵温度(10 ℃、20 ℃、30 ℃、40 ℃、50 ℃和60 ℃)、培养基初始pH值(4.0、4.5、5.0、5.5、6.0)及接种量(1%、2%、3%、4%、5%)置于28 ℃、180 r/min条件下培养2 d,8 000 r/min,离心10 min,测定其发酵上清液于710 nm处测定脂肪酶及蛋白酶活力。
脂肪酶酶活定义:1 mL粗酶液在40 ℃条件下,1 min水解棕榈酸对硝基苯酯生成1 μmol对硝基苯酚所需酶量定义为1个酶活单位(U/mL)[20]。
蛋白酶酶活定义:1 mL粗酶液在40 ℃条件下,1 min水解酪蛋白生成1 μg酪氨酸所需酶量定义为1个酶活单位(U/mL)[21]。
1.3.9 数据分析
采用SPSS22.0软件分析数据,Origin2021软件绘图。
2 结果与分析
2.1 酵母菌的分离及筛选
根据《酵母菌的特征与鉴定手册》[22],从发酵乳制品中分离得到82株具有酵母菌菌落形态的菌株,大多数酵母菌落呈白色或乳白色圆形,边缘整齐,表面平整或饱满略有突起,光滑有光泽,少数菌落呈现半透明状。 在此基础上,测定其脂肪酶和蛋白酶能力。
2.2 产酶酵母菌的筛选
2.2.1 产脂肪酶酵母菌筛选
用三丁酸甘油酯平板筛选脂肪酶酵母菌,共得到46株产透明圈的产脂肪酶酵母菌,其中,16株菌的D/d值较大,其D/d值检测结果见表1。 由表1可知,菌株M19、M26、S03 D/d值≥5.0。
表1 16株产脂肪酶酵母菌D/d值检测结果
Table 1 Determination results of D/d values of 16 strains of lipase-producing yeast

编号D/d 值编号D/d 值编号D/d 值编号D/d 值M19 M26 M04 S03 5.5 5.0 4.8 5.2 M40 M32 M41 S02 4.6 4.1 3.9 3.1 M75 M06 M48 S07 3.5 3.1 2.8 2.9 M29 M54 M80 S08 3.1 3.7 3.9 4.5
2.2.2 产蛋白酶酵母菌筛选
用酪蛋白琼脂培养基筛选蛋白酶酵母菌,共得到12株产透明圈的产蛋白酶酵母菌,其中,12株菌的D/d值较大,其D/d值检测结果见表2。 由表2可知,菌株M19、M26、M04、M40 D/d值≥2.5。
表2 12株产蛋白酶酵母菌D/d值检测结果
Table 2 Determination results of D/d values of 12 strains of protease-producing yeast

编号D/d 值编号D/d 值编号D/d 值编号D/d 值M19 M26 M04 2.6 2.7 2.5 M40 S03 M42 2.5 2.1 1.8 M52 M33 M34 1.6 1.9 2.0 S07 S05 M41 1.4 1.7 1.9
综上,菌株M19、M04、M40、M26、S03为既产脂肪酶又产蛋白酶的酵母菌。因此,对其耐受能力进行进一步分析。
2.3 产酶酵母菌耐受性能分析
筛选菌株葡萄糖、乙醇体积分数及pH值耐受性实验结果见图1。在酒精发酵过程中,糖类物质是酒精发酵的原料,可影响发酵效果[23]。由图1A可知,当葡萄糖含量为10%~50%时,菌株M19及菌株M26的OD600 nm值整体高于其余菌株,菌株M26的OD600 nm值先增加后降低,其余菌株OD600 nm值整体呈下降趋势;当葡萄糖含量为50%时,菌株M19和M26 OD600nm值最高,分别为0.758和0.687。乙醇其分子结构兼具极性羟基和非极性羟基,能够穿微生物细胞膜的脂质双层结构,对生理代谢有一定影响[24],由图1B可知,当乙醇体积分数为5%~13%时,菌株M19及菌株M26的OD600 nm值整体高于其余菌株,呈现下降趋势,菌株M40、M04和S03的OD600 nm值呈快速下降趋势;当乙醇体积分数13%时,菌株M19和M26 OD600nm值最高,分别为0.543和0.615。酵母耐酸性在传统乳制品发酵中是一个重要的评价指标[25-27]。由图1C可知,在pH为2.0~4.0时,菌株M19及菌株M26的OD600 nm值整体高于其余菌株;菌株M26和M19的OD600 nm值呈快速增加趋势,其余菌株OD600nm值增加较为缓慢;当pH值为2.5时,菌株M19和M26 OD600 nm值最高,分别为0.708和0.640。 综上,5株产酶酵母菌中M19和M26的耐受性能最优,可耐受乙醇体积分数13%、pH 2.5、葡萄糖含量50%。

图1 筛选菌株葡萄糖(A)、乙醇体积分数(B)及初始pH值(C)耐受性实验结果
Fig. 1 Results of the tolerance experiments for glucose (A), ethanol volume fraction (B) and initial pH value (C) of the screened strains
2.4 酵母菌发酵液感官评价
产酶酵母菌(M-40、M-04、S-03、M-26、M-19)感官评价结果见图2。由图2可知,菌株M-40、M-04、S-03均产生不良气味,未发觉明显醇香和酯香,总体接受度较低。仅菌株M-26、M-19具有较明显的醇香和酯香,无不良气味。其中,醇香分别达到4分和5分,酯香分别达到5分和6分。因此,对菌株M-26、M-19进行鉴定。

图2 筛选菌株发酵液感官评定雷达图
Fig. 2 Sensory evaluation radar diagram of fermentation broth of screened strains
2.5 产酶酵母菌鉴定
2.5.1 形态学观察
产酶酵母菌M19和M26在YPD固体培养基上的菌落及细胞形态见图3。由图3可知,酵母菌菌落大而厚,呈圆形,菌落表面光滑、黏稠,容易挑起,菌落质地柔软,颜色均一,有光泽,多为乳白色。
图3 菌株M19(A)和M26(B)菌落形态及细胞形态
Fig. 3 Colony morphology and cell morphology of strains M19 (A) and M26 (B)
2.5.2 分子生物学鉴定
基于18S rRNA基因序列菌株M19和M26的系统发育树见图4。

图4 基于18S rRNA基因序列菌株M19和M26的系统发育树
Fig. 4 Phylogenetic tree of strains M19 and M26 based on 18S rRNA gene sequence
由图4可知,菌株M19与马克斯克鲁维酵母(Kluyveromyces marxianus)相似度达99.18%,菌株M26与发酵毕赤酵母(Pichia fermentans)相似度达98.55%。 因此,菌株M19被鉴定为马克斯克鲁维酵母(Kluyveromyces marxianus),菌株M26被鉴定为发酵毕赤酵母(Pichia fermentans)。
2.6 不同产酶酵母菌生长曲线的测定
产酶酵母菌的生长曲线可以反映出在某一时间时其生长状况的变化[28],产酶酵母菌M19及M26的生长曲线见图5。

图5 产酶酵母菌M19及M26的生长曲线
Fig. 5 Growth curves of enzyme-producing yeasts M19 and M26
由图5可知,马克斯克鲁维酵母M19和发酵毕赤酵母M26的生长曲线变化趋势一致:在0~12 h为生长延缓期,此时的菌株处于适应培养环境的过程,在12~24 h菌株呈现对数增长,为对数生长期,24~50 h后菌株生长趋于稳定,逐步进入稳定期,发酵50 h之后,菌株进入衰亡期。 由此可知,2株产酶酵母菌M19和M26最佳接种时间为24 h。
2.7 酵母菌最佳产酶条件优化
培养温度、初始pH值及接种量对产酶活力的影响见图6。由图6A可知,随着温度在10~60 ℃范围内增加,2株菌株产蛋白酶和脂肪酶活性呈先增加后减少的趋势;当培养温度为40 ℃时,菌株M-26及M-19产蛋白酶和脂肪酶酶活力达到最高值,蛋白酶活力分别为32.5 U/mL和33 U/mL,脂肪酶活力分别为28.5 U/mL和40 U/mL。因此,两株菌株最适发酵温度为40 ℃。由图6B可知,随着初始pH值在4~6范围内增加,2株菌株产蛋白酶和脂肪酶活性呈先增加后减少的趋势;当初始pH值5.0时,菌株M-26及M-19产蛋白酶和脂肪酶酶活力达到最高值,蛋白酶活力分别为32 U/mL和36 U/mL,脂肪酶活力分别为39 U/mL和42 U/mL。由图6C可知,随着接种量在1%~5%范围内增加,2株菌株产蛋白酶和脂肪酶活力呈先增加后减少的趋势;当接种量4%时,菌株M-19蛋白酶和脂肪酶酶活力达到最高值,酶活力分别为54 U/mL和48 U/mL,而菌株M-26蛋白酶和脂肪酶酶活力分别为49 U/mL和47 U/mL。

图6 培养温度(A)、初始pH值(B)及接种量(C)对菌株产酶活力的影响
Fig. 6 Effects of culture temperature (A), initial pH values (B) and inoculum (C) on enzyme production activities of the strain
3 结论
本研究以传统发酵乳制品为原料,从中分离筛选出82株酵母菌,采用透明圈法初步筛选产蛋白酶和脂肪酶的菌株,结合耐受性试验以及发酵性能试验复筛,通过形态学观察、分子生物学技术对筛选菌株进行鉴定,并对其生长曲线、最佳产酶条件进行分析。 结果表明,两株产酶酵母菌(M19和M26)分别可耐受乙醇体积分数为13%、pH值2.5、葡萄糖含量50%,具有较明显的醇香和酯香,无不良气味。通过分子生物学鉴定,确定产酶酵母菌M19为马克斯克鲁维酵母(Kluyveromyces marxianus),产酶酵母菌M26为发酵毕赤酵母(Pichia fermentans)。 对2株产酶酵母菌生长曲线进行测定可知,2株产酶酵母菌最佳接种时间为24 h。 酵母菌M19和M26的蛋白酶及脂肪酶活力分别在发酵温度40 ℃、初始pH值5.0、接种量为4%时最高。在此优化条件下,菌株M-19蛋白酶活力及脂肪酶活力(54 U/mL、48 U/mL)略高于菌株M-26(49 U/mL、47 U/mL)。本研究可丰富乳制品微生物资源,为产酶酵母菌菌株的利用提供理论依据。 在后续研究中,将针对产酶酵母菌株M19与M26,深入剖析其在发酵乳制品中对风味物质合成的影响机制及潜在益生功能特性,旨在发掘一株可显著优化发酵乳制品风味轮廓并增强其功能属性的优质菌株。
[1] 中华人民共和国国家卫生健康委员会,国家市场监督管理总局.GB 19302—2025发酵乳[S] .北京:中国标准出版社.
[2] 崔爽,仪垂江,孔凡军,等. 传统发酵乳制品中分离乳酸菌的益生菌特性研究[J] .乳品与人类,2024(1):16-22.
[3] 王淑梅,宋倩倩,王晓磊,等. 传统发酵乳制品中乳酸菌的分离及鉴定[J] .粮食与油脂,2021,34(2):5-7,17.
[4] 杨荞玮.酵母菌的应用研究进展[J] .中国食品工业,2024(4):131-133.
[5] 廖一漠,敖晓琳,康海燕,等. 传统发酵食品中乳酸菌与酵母菌互作机制研究进展[J] .食品与发酵工业,2023,49(3):340-346.
[6] JOHNSON M, LUCEY J. Major technological advances and trends in cheese[J] .J Dairy Sci,2006,89(4):1174-1178.
[7] 王梓桐,刘堉萍,汪超,等. 乳酸菌与酵母菌联合发酵改善食品品质研究进展[J] .中国酿造,2023,42(10):12-17.
[8] DE FREITAS I,PINON N,MAUBOIS J L,et al.The addition of a cocktail of yeast species to cantalet cheese changes bacterial survival and enhances aroma compound formation[J] .Int J Food Microbiol,2009,129:37-42.
[9] GORI K,MORTENSEN H D,ARNEBORG N,et al.Ammonia production and its possible role as a mediator of communication for Debaryomyces hansenii and other cheese-relevant yeast species[J] .J Dairy Sci,2007,90(11):5032-5041.
[10] THIERRY A, COLLINS Y F, MUKDSI M C A, et al. Lipolysis and metabolism of fatty acids in cheese[M] //Cheese. Academic Press:New York,2017:423-444.
[11] KHATTAB A R,GUIRGUIS H A,TAWFIK S M,et al.Cheese ripening:A review on modern technologies towards flavor enhancement,process acceleration and improved quality assessment[J] .Trends Food Sci Tech,2019,88:343-360.
[12] 张晓旭,葛武鹏,梁秀珍,等. 内蒙古和新疆牧区酸马奶中酵母菌的多样性及其优势菌发酵特性[J] .食品科学,2016,37(17):156-162.
[13] 李宇辉,郭安民,刘成江,等.伊犁牧区传统发酵乳制品中产香酵母菌的分离及香气成分分析[J] .食品与发酵工业,2016,42(11):179-184.
[14] 刘飞,郑晓吉,李宝坤,等.新疆哈萨克族奶酪产脂肪酶酵母菌的筛选及产酶条件优化[J] .食品与机械,2018,34(3):54-58.
[15] 乔传丽,金丹,蒋艾廷,等.传统发酵酸牛奶中产蛋白酶酵母菌的筛选及产酶条件优化[J] .食品与生物技术学报,2019,38(5):73-78.
[16] 马延琴,徐晓裕,李甜,等. 酿酒葡萄表皮产酶非酿酒酵母的筛选及其产酶特性研究[J] .中国酿造,2021,40(12):149-154.
[17] 樊扬. 川西传统发酵牦牛乳中酵母菌的分离鉴定及其在醇香酸奶中的应用[D] .雅安:四川农业大学,2021.
[18] 马文锦,李梅林,王博,等.胶红酵母Rhodotorula mucilaginosa CM-1菌株的鉴定及胞外多糖的分离纯化[J] .食品与发酵工业,2021,47(21):46-52.
[19] 柴洋洋,葛菁萍,宋刚,等. 传统发酵豆酱中酵母菌的分离、筛选及功能酵母的鉴定[J] .中国食品学报,2013,13(3):183-188.
[20] MARGESIN R, FELLER G, HÄMMERLE M, et al. A colorimetric method for the determination of lipase activity in soil[J] .Biotechnol Lett,2002,24:27-33.
[21] 曹慧,张腾月,赵龙妹,等. 土壤中高产蛋白酶菌株产酶条件及酶学性质[J] .微生物学通报,2020,47(7):2072-2081.
[22] 巴尼特J A.酵母菌的特征与鉴定手册[M] . 青岛:青岛海洋大学出版社,1991.
[23] WANG J, YANG Z J, WANG Y D, et al. The key aroma compounds and sensory characteristics of commercial Cheddar cheeses[J] .J Dairy Sci,2021,104(7):7555-7571.
[24] LOURENCO A B, ROQUE F C, TEIXEIRA M C, et al. Quantitative 1H-NMR-metabolomics reveals extensive metabolic reprogramming and the effect of the aquaglyceroporin FPS1 in ethanol-stressed yeast cells[J] .PloS ONE,2013,8(2):355-439.
[25] 唐弦,武运,田甜,等. 伊犁地区发酵酸马乳优良酵母菌的筛选及其发酵性能研究[J] .中国酿造,2024,43(10):42-48.
[26] ALMENA-ALISTE M,MIETTON B.Cheese classification, characterization, and categorization:a global perspective[J] . Microbiol Spectr,2014,2(1):CM-0003-2012.
[27] 刘飞,姜蕾,丁真真,等. 发酵驴乳中酵母菌的分离鉴定及发酵特性研究[J] .中国调味品,2023,48(12):75-78,97.
[28] 李丹丹.西藏传统牦牛乳制品中抗氧化乳酸菌的筛选及发酵性能研究[D] .拉萨:西藏大学,2020.